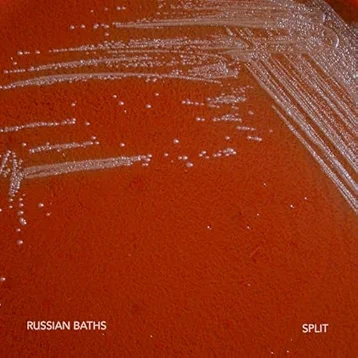

ニューヨーク/ブルックリン拠点のオルタナティヴロックバンド Russian Bathsが、3/20にGood Eye Recordsからリリースしたニューシングル 'Split'のMVを公開!
Russian Bathsは Jess Rees (Activity), Luke Koz, Kyle Garveyの3人組。
2019年にデビューアルバム『Deepfake』を発表し、これまでに Black Midi, Drahla, Priests, The Horrors, Marissa Nadler, We Are Scientists, Bambaraなどと共演してます。
'Split'は6/14発売のニューアルバム『Mirror』収録曲。
ノイズと不気味なサウンドスケープが特徴のバンド。ノイズロック〜シューゲイズ周辺がメインだけど、曲によってはポストパンクからDCハードコア、ミッドウェストエモまで表現の幅が広いです。
“People copy people. People are copies of people. People avoid their reflections. People are reflections of other people. People don’t look at people unless they really want to, even if you give them money.”